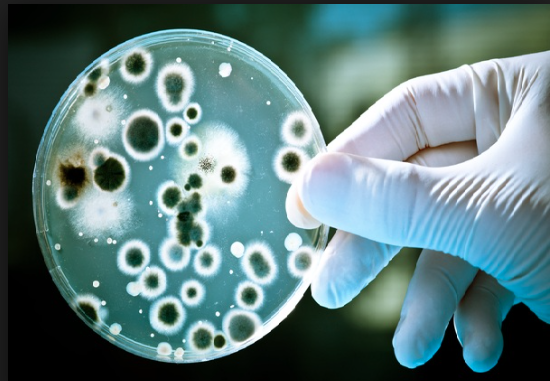

-
 play_arrow
play_arrow
City FM 103,8
-
 play_arrow
play_arrow
ΔΙΑΥΛΟΣ 99.2 FM
-
 play_arrow
play_arrow
Κανάλι 20 107,5
Τα -ολοένα πιο ανθεκτικά στα αντιβιοτικά- μικρόβια θα σκοτώνουν έναν άνθρωπο κάθε τρία δευτερόλεπτα, κάπου στον πλανήτη μας έως το 2050, προειδοποιεί μια νέα διεθνής έκθεση, η οποία καλεί κυβερνήσεις, φαρμακευτικές εταιρείες και επιστήμονες να εντείνουν τις προσπάθειές τους.
Σύμφωνα με τη βαρυσήμαντη έκθεση, η ιατρική απειλείται «να επιστρέψει στο σκοτεινό μεσαίωνα», αν δεν επενδυθούν δισεκατομμύρια δολάρια (έως 40 δισ. δολ. την επόμενη δεκαετία) για να λυθεί το πρόβλημα της μικροβιακής αντίστασης όχι μόνο στα αντιβιοτικά, αλλά και σε όλα τα αντιμικροβιακά φάρμακα κατά ιών, μυκήτων, παρασίτων και άλλων παθογόνων μικροοργανισμών.
Οι παγκόσμιες πωλήσεις αντιβιοτικών με πατέντα είναι περίπου 4,7 δισεκατομμύρια δολάρια, ετησίως. Η έκθεση, με δυό λόγια, προτείνει να μειωθεί η ζήτηση για αντιβιοτικά και άλλα αντιμικροβιακά φάρμακα και, παράλληλα, να αυξηθεί η προσφορά τους.
Για τον λόγο αυτό, προτείνει την αποζημίωση με τουλάχιστον ένα δισεκατομμύριο δολάρια των φαρμακοβιομηχανιών για κάθε νέο αντιβιοτικό που θα ανακαλύπτουν, αλλά και την επιβολή πρόσθετων φόρων σε εκείνες τις εταιρείες που δεν επενδύουν στην έρευνα για νέα αντιβιοτικά.
Η τελευταία αυτή ιδέα ήδη απορρίφθηκε από την Ένωση Βρετανικής Φαρμακοβιομηχανίας, αν και μεμονωμένες εταιρείες που παράγουν αντιβιοτικά, όπως η GlaxoSmithKline, εμφανίσθηκαν μάλλον θετικές.
Η έκθεση, που συντάχθηκε μετά από προτροπή πριν δύο χρόνια του βρετανού πρωθυπουργού Ντέηβιντ Κάμερον, σύμφωνα με το BBC, το πρακτορείο Ρόιτερς και το “Science”, κάνει λόγο για την ανάγκη να υπάρξει μια «επανάσταση» στον τρόπο που χρησιμοποιούνται τα αντιβιοτικά.
Γι’ αυτό, προτείνει μια εκτεταμένη καμπάνια ενημέρωσης της παγκόσμιας κοινής γνώμης, καθώς οι περισσότεροι άνθρωποι δεν έχουν επίγνωση των επερχόμενων κινδύνων, με συνέπεια να παίρνουν αντιβιοτικά ακόμη και για απλά κρυολογήματα.
Στο πλαίσιο αυτό, προτείνεται από το 2020 σε κανένα ασθενή να μην συνταγογραφούνται αντιβιοτικά, αν προηγουμένως δεν έχει γίνει ένα σχετικό γρήγορο τεστ, που να επιβεβαιώνει ότι όντως τα χρειάζεται. Για να γίνει αυτό όμως, θα πρέπει πρώτα να εξαπλωθούν ευρέως αυτά τα γρήγορα τεστ.
Η ανθρωπότητα, σύμφωνα με τους συντάκτες της έκθεσης, χάνει σταδιακά τη μάχη των αντιβιοτικών, που θεωρείται εξίσου σοβαρή με τη μάχη κατά της τρομοκρατίας. Το πρόβλημα είναι διπλό: δεν ανακαλύπτονται νέα αποτελεσματικότερα αντιβιοτικά με τον αναγκαίο ρυθμό (η πιο πρόσφατη κατηγορία νέων αντιβιοτικών ανακαλύφθηκε στη δεκαετία του ΄80), ενώ «σπαταλιούνται» και έτσι αχρηστεύονται τα υπάρχοντα αντιβιοτικά λόγω άλογης χρήσης.
Ήδη έχουν εμφανισθεί μικρόβια που αντιστέκονται ακόμη και στα ισχυρότερα αντιβιοτικά «τελευταίας καταφυγής», όπως η κολιστίνη, με συνέπεια ο κόσμος να βρίσκεται ενώπιον μιας «εποχής χωρίς αντιβιοτικά», που θα ισοδυναμεί με μια «Αποκάλυψη» σε θρησκευτικούς όρους.
Η έκθεση προβλέπει ότι δέκα εκατομμύρια άνθρωποι θα πεθαίνουν κάθε χρόνο έως το 2050 εξαιτίας λοιμώξεων από ανθεκτικά μικρόβια (έναντι 700.000 ετησίως σήμερα), ενώ το κόστος για την παγκόσμια οικονομία λόγω της μαζικής αντίστρασης στα αντιβιοτικά θα φθάσει στα 100 τρισεκατομμύρια δολάρια έως τα μέσα του αιώνα μας.
Μεταξύ άλλων, η έκθεση προτείνει τη μείωση της υπερβολικής χρήσης αντιβιοτικών στην κτηνοτροφία (στις ΗΠΑ το 70% των πωλούμενων αντιβιοτικών καταλήγουν σε ζώα) και την επιβολή σήμανσης στα προϊόντα κρέατος που έχουν προκύψει από ζώα με αντιβιοτικά. Επίσης, τη δημιουργία ενός νέου Παγκόσμιου Ταμείου Καινοτομίας ύψους δύο δισεκατομμυρίων δολαρίων (το οποίο θα χρηματοδοτεί έρευνες για νέα αντιβιοτικά), τη βελτίωση των συνθηκών υγιεινής στα νοσοκομεία, τη προώθηση της χρήσης εμβολίων ως εναλλακτικών στα αντιβιοτικά κ.α.
Ο λόρδος Τζιμ Ο’Νιλ, επικεφαλής της έκθεσης και πρώην επικεφαλής οικονομολόγος της Goldman Sachs, δήλωσε ότι «πρέπει να μεταφέρουμε σε όλο τον κόσμο το μήνυμα πως είναι κρίσιμο να σταματήσουμε να αντιμετωπίζουμε τα αντιβιοτικά σαν γλυκά. Αν δεν λύσουμε το πρόβλημα, οδεύουμε προς μια σκοτεινή εποχή ξανά, όπου πολλοί άνθρωποι θα πεθαίνουν».
Σε ένα τέτοιο μέλλον, που θυμίζει σενάριο επιστημονικής φαντασίας και όπου οι γιατροί δεν θα διαθέτουν πια το «όπλο» των αντιβιοτικών, ακόμη και μια χειρουργική επέμβαση ρουτίνας (π.χ. σκωληκοειδίτιδας) μπορεί να αποβαίνει θανατηφόρα. Οι αντικαρκινικές θεραπείες ή οι μεταμοσχεύσεις οργάνων θα σκοτώνουν πολλούς ασθενείς. Η παιδική θνησιμότητα θα εκτοξευθεί ξανά στα ύψη.
Ο Παγκόσμιος Οργανισμός Υγείας και άλλοι διεθνείς φορείς επαίνεσαν τη νέα έκθεση, όμως οι Γιατροί Χωρίς Σύνορα δήλωσαν ότι «αν και αποτελεί ένα σημαντικό πρώτο βήμα για να αντιμετωπισθεί η ευρεία αποτυχία της αγοράς σε αυτό το πεδίο, δεν πηγαίνει τόσο μακριά, όσο χρειάζεται».
Πηγή: usay.gr
Συντάχθηκε από: MESSINIA RADIO
άνθρωπο δευτερόλεπτα κάθε σκοτώνουν σοκ τρία
Σχετικά άρθρα
www.Messiniawebtv.gr
Players




CITY FM 103.8
ΔΙΑΥΛΟΣ 99.2 FM

Mpourmpoulithres
With Malika
For every Show page the timetable is auomatically generated from the schedule, and you can set automatic carousels of Podcasts, Articles and Charts by simply choosing a category. Curabitur id lacus felis. Sed justo mauris, auctor eget tellus nec, pellentesque varius mauris. Sed eu congue nulla, et tincidunt justo. Aliquam semper faucibus odio id varius. Suspendisse varius laoreet sodales.
close
Mpourmpoulithres
With Malika
For every Show page the timetable is auomatically generated from the schedule, and you can set automatic carousels of Podcasts, Articles and Charts by simply choosing a category. Curabitur id lacus felis. Sed justo mauris, auctor eget tellus nec, pellentesque varius mauris. Sed eu congue nulla, et tincidunt justo. Aliquam semper faucibus odio id varius. Suspendisse varius laoreet sodales.
closeChart
-
-
 play_arrow
play_arrow
Dancing In The Flames The Weeknd
-
-
-
 play_arrow
play_arrow
Se Periptosi Pou Anna Vissi
-
-
-
 play_arrow
play_arrow
Bad Dreams Teddy Swims
-
-
-
 play_arrow
play_arrow
Xiliometra APON
-
-
-
-
 play_arrow
play_arrow
Koino Mistiko (feat. Lila) LILA
-
-
-
 play_arrow
play_arrow
Messy Lola Young
-
-
-
 play_arrow
play_arrow
I Adore You (feat. Daecolm) HUGEL, Topic & Arash
-
-
-
 play_arrow
play_arrow
Gyrismos Christos Mastoras & Melisses
-
Top popular

Αμπαζής & Γεννατάς στις 13 Μαρτίου στο Yiamas Gastro Bar!

Δείτε ζωντανή εικόνα ΤΩΡΑ από την κεντρική πλατεία Καλαμάτας ( Live Video Streaming)

O πιο διάσημος Έλληνας πορνοστάρ αποκαλύπτει όλα του τα μυστικά!

Καλοκαιρινή Πολιτιστική Ατζέντα Καλαμάτας 2025: Όλες οι εκδηλώσεις που δεν πρέπει να χάσετε!

30 πρόστυχα μηνύματα για να ανάψεις έναν άντρα!
Kanali 20
COPYRIGHT © 2015 - 2025 MESSINIARADIO.GR | POWERED BY SLAVE IT SOLUTIONS